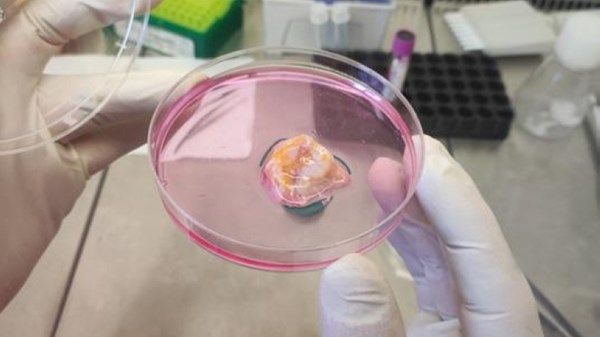
«أبوظبي للخلايا الجذعية» يطلق علاجاً مبتكراً للسرطان

ابوظبي - سيف اليزيد - أبوظبي (الاتحاد)
أعلن مركز أبوظبي للخلايا الجذعية (ADSCC) عن إنجاز طبي رائد يمثل قفزة نوعية في علاج السرطان، بعد نجاحه للمرة الأولى في عزل الخلايا اللمفاوية المتسللة إلى الأورام (TILs) من عينات أورام الثدي والرئة، تمهيداً لإطلاق أول برنامج من نوعه في دولة الإمارات والعالم العربي في هذا المجال.
ويُعد هذا الإنجاز الرائد خطوة استراتيجية نحو تطوير علاج مناعي متقدم يعتمد على خلايا المريض نفسه لمحاربة السرطان، حيث يُعتبر علاج الـ(TILs) أحد أكثر أساليب العلاج الشخصي الواعدة، لما أظهره من نتائج استثنائية في مكافحة الأورام السرطانية.
ويجري هذا المشروع ضمن دراسة رصدية معتمدة من دائرة الصحة – أبوظبي.
وعلى عكس العلاجات التقليدية مثل العلاج الكيميائي، التي قد تؤثر على الخلايا السليمة والمريضة معاً، يعمل علاج الـTILs الخلايا اللمفاوية المتسللة إلى الأورام على تحفيز جهاز المناعة الطبيعي في الجسم.
وتتمثل آليته في استخراج الخلايا المناعية من عينة الورم، ثم تنميتها بمليارات الخلايا في مختبرات متطورة، قبل إعادة حقنها في جسم المريض لاستهداف الخلايا السرطانية بدقة عالية. وحول الموضوع نفسه، قالت الدكتورة زيمة موزورا هريرا، العالمة الرئيسية في مشروع الخلايا اللمفاوية المتسللة إلى الأورام (TILs) بمركز أبوظبي للخلايا الجذعية: «نحن نحول ورم المريض نفسه إلى جيش شخصي لمحاربة السرطان.
فهذه الخلايا مدرّبة بطبيعتها للتعرف على هذا النوع من السرطان، ودورنا هو عزلها وتكثيرها بشكل كبير في المختبر، ثم إعادتها إلى الجسم لتؤدي وظيفتها بكفاءة. إنه علاج حي، مصمم خصيصاً لكل مريض».
وقد أثبت هذا العلاج فعالية مميزة في علاج سرطان الجلد (الميلانوما)، كما يُظهر نتائج واعدة في أنواع أخرى من الأورام الصلبة مثل سرطان عنق الرحم والرئة وسرطان الرأس والعنق.
وبالنسبة للمرضى الذين استنفدوا خياراتهم العلاجية، يُمثل علاج الـTILs الخلايا اللمفاوية المتسللة إلى الأورام أملاً جديداً وحقيقياً في مواجهة المرض.
ويأتي هذا الإعلان، ليجسد روح الابتكار والتطور التي تميّز مسيرة الدولة. كما يؤكد هذا الإنجاز التزام مركز أبوظبي للخلايا الجذعية بتوفير أحدث العلاجات الطبية عالمياً داخل الدولة، دون الحاجة إلى سفر المرضى للخارج، وتعزيز مكانة الإمارات كمركز رائد للابتكار الطبي. ويتميز المركز بمختبراته المتوافقة مع معايير ممارسات التصنيع الجيد (GMP)، إضافة إلى بروتوكولات السلامة الصارمة التي تضمن إنتاج العلاج وفق أعلى المعايير العالمية.
ويؤسس هذا الإنجاز لمرحلة جديدة تشمل إنتاج الخلايا اللمفاوية المتسللة إلى الأورام وخلايا TCR المعدلة وراثياً على نطاق صناعي، تمهيداً لإطلاق تجارب سريرية مستقبلية.
وفي هذا الصدد، قال البروفيسور يندري فينتورا، الرئيس التنفيذي لمركز أبوظبي للخلايا الجذعية: «هذا ليس مجرد علاج جديد، بل هو نموذج جديد كلياً في رعاية مرضى السرطان في الإمارات والمنطقة.
فمن خلال تطوير هذا العلاج محلياً، نوفر لمرضانا خياراً علاجياً متقدماً، ونساهم في إثراء المعرفة العلمية عالمياً.
كما يمثل هذا البرنامج خطوة فخر واعتزاز لوطننا، كما ينسجم تماماً مع الرؤية الريادية التي نقترب من الاحتفال بها في اليوم الوطني لدولة الإمارات». ويعتزم مركز أبوظبي للخلايا الجذعية خلال المرحلة المقبلة إطلاق دراسات سريرية لجمع عينات الأورام الأولية، تمهيداً لتوسيع نطاق العلاج وإتاحته للمرضى المؤهلين في دولة الإمارات من خلال التجارب السريرية المستقبلية.



